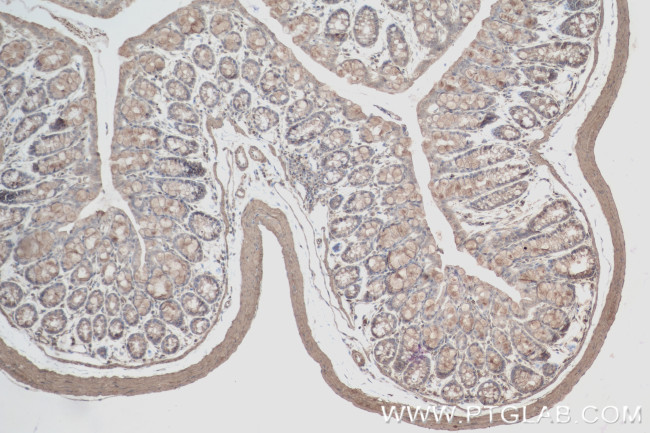
PARP14 Antibody in Immunohistochemistry (Paraffin) (IHC (P))

Search
Proteintech
PARP14 Recombinant Rabbit Monoclonal Antibody (241078C11)
{{$productOrderCtrl.translations['antibody.pdp.commerceCard.promotion.promotions']}}
{{$productOrderCtrl.translations['antibody.pdp.commerceCard.promotion.viewpromo']}}
{{$productOrderCtrl.translations['antibody.pdp.commerceCard.promotion.promocode']}}: {{promo.promoCode}} {{promo.promoTitle}} {{promo.promoDescription}}. {{$productOrderCtrl.translations['antibody.pdp.commerceCard.promotion.learnmore']}}
产品信息
84039-6-RR
种属反应
宿主/亚型
Expression System
分类
类型
克隆号
抗原
偶联物
形式
浓度
纯化类型
保存液
内含物
保存条件
运输条件
产品详细信息
Immunogen sequence: SRDVMQARD EIEAMIKRVR LAKEQESRAD CISEFIEWQY NDNNTSHCFN KMTNLKLEDA RREKKKTVDV KINHRHYTVN LNTYTATDTK GHSLSVQRLT KSKVDIPAHW SDMKQQNFCV VELLPSDPEY NTVASKFNQT C
靶标信息
Poly [ADP-ribose] polymerase 14 (PARP14) is a B aggressive lymphoma protein belonging to the PARP protein family. Poly ADP ribosylation is a DNA damage dependent post translational modification of histones and other nuclear proteins that mediates DNA repair. PARP proteins with a macrodomain are also involved in gene expression through transcriptional regulation. PARP14 controls STAT6 dependent transcription by enhancing binding to the promoter in the presence of a positive signal (i.e. IL4 stimulation).
仅用于科研。不用于诊断过程。未经明确授权不得转售。
篇参考文献 (0)
生物信息学
蛋白别名: ADP-ribosyltransferase diphtheria toxin-like 8; ARTD8; B aggressive lymphoma protein 2; B-aggressive lymphoma 2; CoaSt6; Collaborator of STAT6; PARP-14; Poly [ADP-ribose] polymerase 14; Protein mono-ADP-ribosyltransferase PARP14
基因别名: 1600029O10Rik; ARTD8; BAL2; BC021340; CoaSt6; KIAA1268; mKIAA1268; PARP-14; PARP14; pART8
UniProt ID: (Human) Q460N5, (Mouse) Q2EMV9
Entrez Gene ID: (Human) 54625, (Mouse) 547253